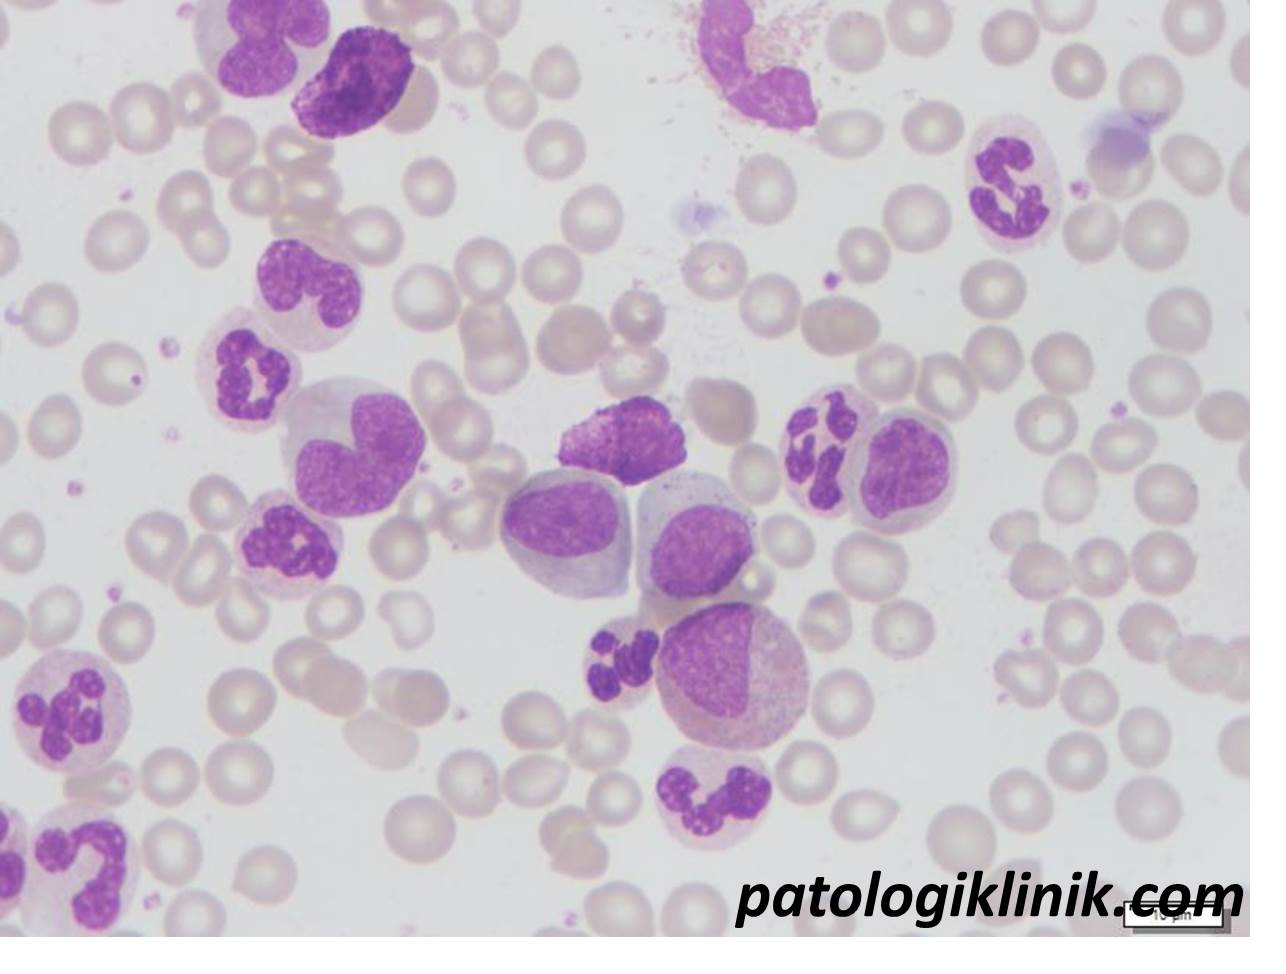
Pemeriksaan I/T Ratio

Smudge Cells, Bukan Sekedar Artefak Hapusan Darah
Smudge cells atau kadang disebut basket cells merupakan salah satu artefak hapusan darah tepi yang sudah dikenal sejak tahun 1896. Gambarannya berupa sisa-sisa leukosit, terutama inti, tanpa struktur sitoplasma berbentuk seperti noda berlepotan akibat gesekan ujung kaca preparat saat pembuatan hapusan. Gambaran smudge cells dapat ditemukan pada beberapa keadaan, diantaranya: